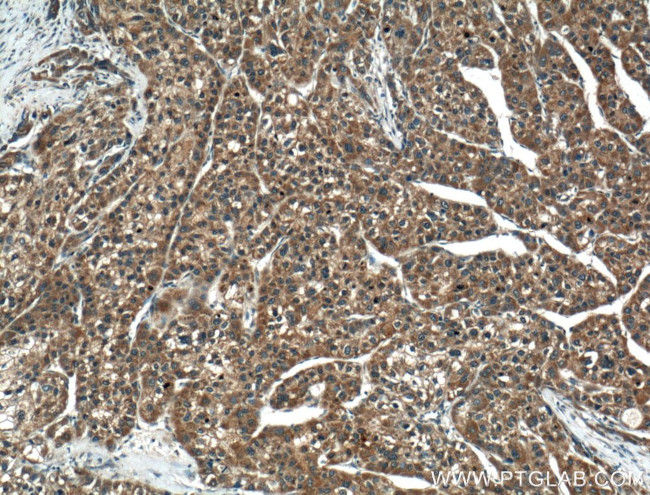
TMEM195 Antibody in Immunohistochemistry (Paraffin) (IHC (P))
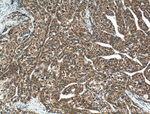
TMEM195 Antibody in Immunohistochemistry (Paraffin) (IHC (P))

Search
Proteintech
TMEM195 Polyclonal Antibody
{{$productOrderCtrl.translations['antibody.pdp.commerceCard.promotion.promotions']}}
{{$productOrderCtrl.translations['antibody.pdp.commerceCard.promotion.viewpromo']}}
{{$productOrderCtrl.translations['antibody.pdp.commerceCard.promotion.promocode']}}: {{promo.promoCode}} {{promo.promoTitle}} {{promo.promoDescription}}. {{$productOrderCtrl.translations['antibody.pdp.commerceCard.promotion.learnmore']}}
产品信息
21355-1-AP
种属反应
已发表种属
宿主/亚型
分类
类型
抗原
偶联物
形式
浓度
规格
纯化类型
保存液
内含物
保存条件
运输条件
产品详细信息
Immunogen sequence: HRMAHEVNI MWAGHQTHHS SEDYNLSTAL RQSVLQIYTS WIFYSPLALF IPPSVYAVHL QFNLLYQFWI HTEVINNLGP LELILNTPSH HRVHHGRNRY CIDKNYAGVL IIWDKIFGTF EAENEKVVYG LTHPINTFEP IKVQFHHLFS IWTTFWATPG FFNKFSVIFK GPGWGPGKPR LGLSEEIPEV TGKEVPFSSS SSQ (132-333 aa encoded by BC108676)
靶标信息
AGMO gene ontology annotations related to this gene include ether lipid metabolic process; lipid biosynthetic process; membrane lipid metabolic process.
仅用于科研。不用于诊断过程。未经明确授权不得转售。
生物信息学
蛋白别名: Alkylglycerol monooxygenase; glyceryl-ether monooxygenase; Transmembrane protein 195; unnamed protein product
基因别名: A530016O06Rik; AGMO; AI790538; TMEM195
UniProt ID: (Human) Q6ZNB7, (Mouse) Q8BS35
Entrez Gene ID: (Human) 392636, (Mouse) 319660